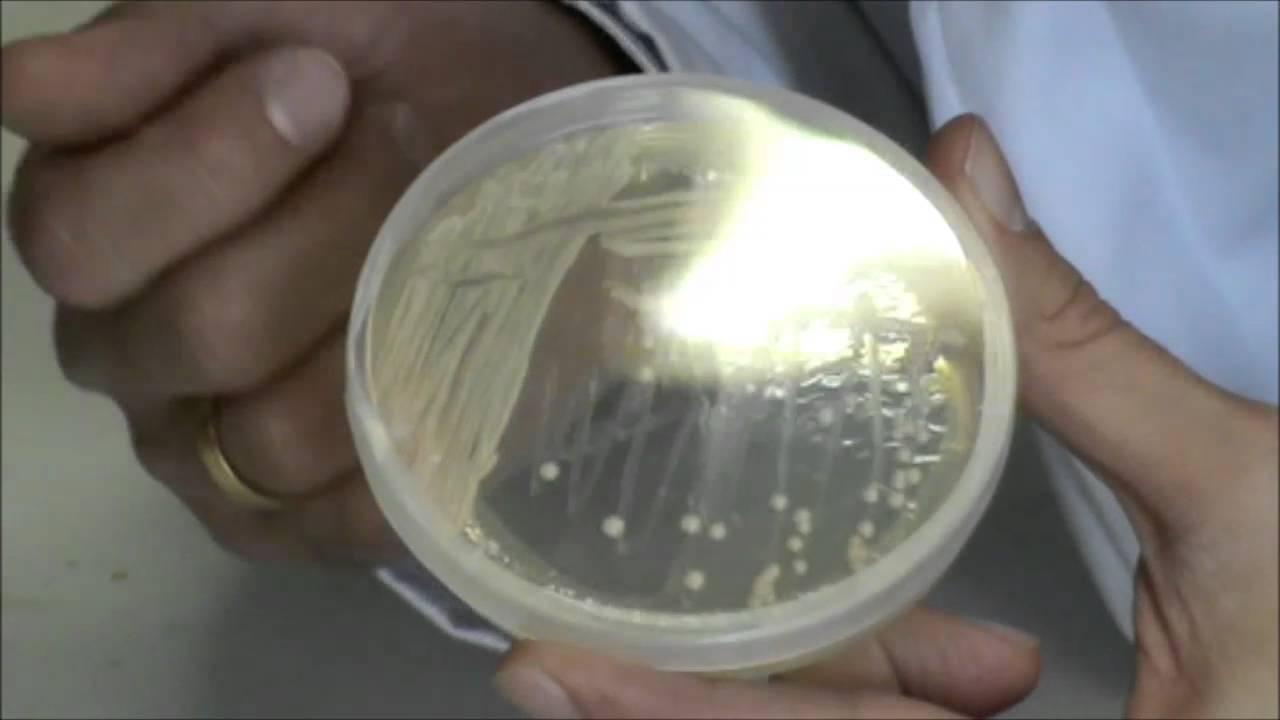
Técnicas básicas de Microbiología Apariencia de

Se denomina cultivo puro o axénico al que contiene sólo un tipo de microorganismo, éstos se inician a partir de colonias aisladas, de manera que todos los individuos provengan del mismo linaje. Los cultivos puros son esenciales para estudiar las características metabólicas e identificarlos.. Es un medio de cultivo rico, diseñado.. Un cultivo que solo contiene un tipo de organismo, es denominado cultivo puro. Algunas muestras clínicas tomadas, por lo general, en ambientes esterilizados, como la sangre o líquidos cefalorraquídeos, ya son de por sí cultivos puros. Las muestras de sitios con una microflora diversa, como muestras nasales o muestras de heces, son.

Calaméo Cultivo Puro

Importancia del pH para los cultivos Productos para Agricultura Hanna Instruments

Microbiología Medios de cultivo

Hispanagar ¿Por qué se utiliza el agar en microbiología?

Medios de cultivo, paso clave en la identificación de Behner SAS

Técnicas de cultivo celular y mediosibiantechnologies

Cultivos en Microbiología Clínica. Dr Alejandro Macias. YouTube

PPT Técnicas de cultivo PowerPoint Presentation, free download ID5369271

Medios de Cultivo de M.Strempler Microbiología, Medio de cultivo, Placas de petri

Calaméo Obtención De Un Cultivo Puro Microbiología
Grupo B de Microbiología de la FCQ Actividad 08; Efecto de Factores Ambientales

Cultivo bacteriano en placa Petri. Divulgación científica (IQOGCSIC) YouTube

Crecimiento De Colonias De Bacterias En Placa Del Medio De Cultivo Imagen de archivo Imagen de

Los 20 medios de cultivo para bacterias (características y aplicaciones)

Cultivo de bacterias Laboratorios González
Técnicas básicas de Microbiología Apariencia de Saccharomyces cerevisiae en cultivo puro YouTube

Microbiología!!👩🔬🔬 Siembra por agotamiento en estría

microbiologia MEDIOS DE CULTIVO

Microbiología Biologia y sus ramas. Wiki Fandom

Free Escherichia coli Stock Photo
de las que se conseguirá un cultivo puro. Una vez obtenidos los cultivos puros se podrán estudiar las características macroscópicas, microscópicas, fisiológicas, etc. un microorganismo en particular. de Hay que tener en cuenta que siempre el aislamiento se da en un medio sólido. El medio líquido sirve para enriquecer, pero no para aislar.. Una de las técnicas más usadas en el laboratorio de microbiología consiste en transferir una muestra microbiológica de un ambiente determinado a un medio de cultivo, lo que permite obtener cultivos microbianos. A l efectuar este procedimiento, es necesario considerar que en el área de trabajo, existen muchos otros microorganismos; debido a.




